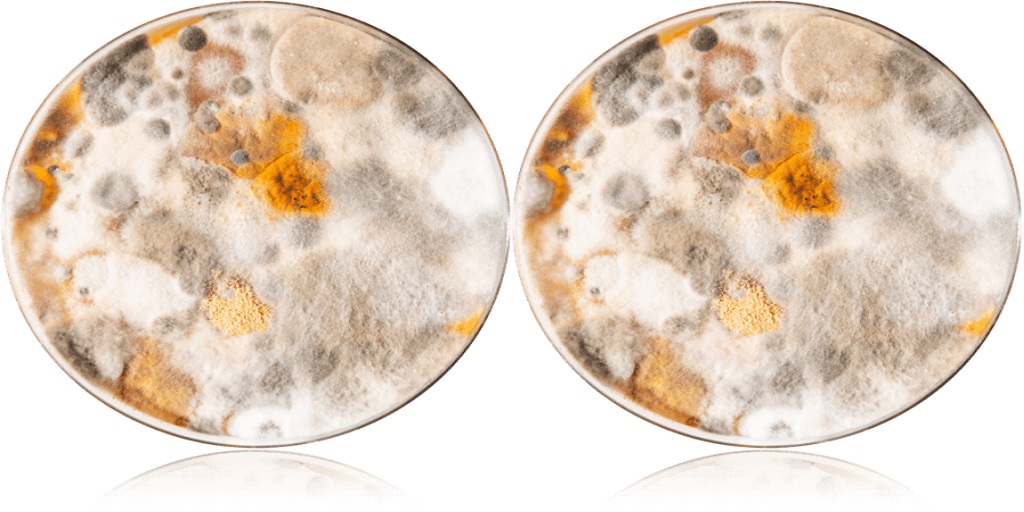

Your attic: a treasure trove of forgotten holiday decorations, childhood mementos, and maybe even a dusty board game or two.
But beyond the nostalgia, your attic can also harbor a hidden enemy – mold.
Mold spores thrive in warm, damp environments, and attics – often poorly ventilated and prone to condensation – can become breeding grounds for these unwelcome guests.
The problem with attic mold is that it can often go undetected for years. Since most people don’t frequent their attics regularly, the telltale signs of mold growth – a musty odor, visible discoloration, or respiratory irritation – might go unnoticed.
However, leaving attic mold unchecked can pose health risks and lead to structural damage to your home.
Can Home Mold Test Kits Help Detect Attic Mold?
Fortunately, there’s a simple and effective way to check for attic mold: home mold test kits. These kits, like the EC3 Mold Screening Test Kit from Micro Balance Health Products, allow you to take air samples or swab surfaces suspected of harboring mold spores.
The kits typically come with easy-to-follow instructions and include test plates that provide visual results within a few days.
Here’s how home mold test kits can be particularly helpful for attic mold detection:
● Easy Accessibility: Attics can be tight spaces with limited access. Home mold test kits are compact and user-friendly, allowing you to collect samples even in cramped attic quarters.
● Targeted Testing: Mold spores can settle on various surfaces in your attic. Home test kits allow you to sample from specific areas you suspect might be moldy, like insulation or roof rafters.
● Peace of Mind: The uncertainty of potential mold growth can be stressful. Home mold test kits provide a preliminary assessment, giving you a clearer picture of the situation in your attic.
Using Home Mold Test Kits Effectively in Your Attic
While home mold test kits are a valuable tool, it’s important to understand their limitations:
● They Don’t Identify Mold Species: Home test kits typically indicate the presence or absence of mold, but not the specific type. If your test results are positive, you can send your test plates into the lab for professional analysis to identify the mold species.
● Placement Matters: Mold spores can settle unevenly in your attic. Strategic placement of test plates is crucial for accurate results. Consider placing test plates near potential moisture sources like roof leaks or condensation buildup.
● Not a Substitute for Professional Inspection: Home mold test kits offer a starting point, but they can’t replace a professional inspection by a mold remediation specialist. If your home test kit reveals mold growth, it’s essential to call in a professional to assess the extent of the problem and recommend a safe and effective remediation plan.
Taking Action After a Positive Test Result
If your home mold test kit reveals the presence of mold in your attic, don’t panic! Here are some steps you can take:
● Isolate the Area: Limit access to the attic to prevent further mold spore dispersal throughout your home.
● Improve Ventilation: Increase air circulation in your attic by opening windows or installing vents.
● Address Moisture Issues: Identify and address any sources of moisture in your attic, such as leaky roofs or condensation problems.
● Consider Professional Help: For extensive mold growth or if you’re unsure about how to proceed, consult a professional mold remediation company.
Don’t Let Your Attic Become a Mold Shelter
By using home mold test kits proactively and taking steps to address potential moisture issues, you can keep your attic mold-free and protect your home and your health.
Micro Balance Health Products offers a variety of home mold test kits, including the EC3 Mold Screening Test Kit, to help you take control of your indoor environment.
Remember, early detection is key to preventing costly repairs and safeguarding the well-being of your family.

